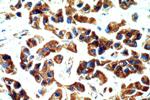
STARD3NL Antibody in Immunohistochemistry (Paraffin) (IHC (P))

Search
Proteintech
STARD3NL Polyclonal Antibody
{{$productOrderCtrl.translations['antibody.pdp.commerceCard.promotion.promotions']}}
{{$productOrderCtrl.translations['antibody.pdp.commerceCard.promotion.viewpromo']}}
{{$productOrderCtrl.translations['antibody.pdp.commerceCard.promotion.promocode']}}: {{promo.promoCode}} {{promo.promoTitle}} {{promo.promoDescription}}. {{$productOrderCtrl.translations['antibody.pdp.commerceCard.promotion.learnmore']}}
产品信息
20502-1-AP
种属反应
宿主/亚型
分类
类型
抗原
偶联物
形式
浓度
规格
纯化类型
保存液
内含物
保存条件
运输条件
产品详细信息
Immunogen sequence: ILAWIETWF LDFKVLPQEA EEENRLLIVQ DASERAALIP GGLSDGQFYS PPESEAGSEE AEEKQDSEKP LLEL (162-234 aa encoded by B C005959)
靶标信息
This gene encodes a late-endosomal protein that contains a conserved MENTAL (MLN64 N-terminal) domain. The encoded protein binds cholesterol molecules and may play a role in endosomal cholesterol transport through interactions with metastatic lymph node protein 64 (MLN64).
仅用于科研。不用于诊断过程。未经明确授权不得转售。
生物信息学
蛋白别名: MGC3251; MLN64 N-terminal domain homolog; MLN64 N-terminal homolog; STARD3 N-terminal-like protein; unnamed protein product
基因别名: 0610035N01Rik; 6530409L22Rik; AW124774; MENTHO; STARD3NL; UNQ855/PRO1864
UniProt ID: (Human) O95772, (Mouse) Q9DCI3
Entrez Gene ID: (Human) 83930, (Mouse) 76205, (Rat) 291182